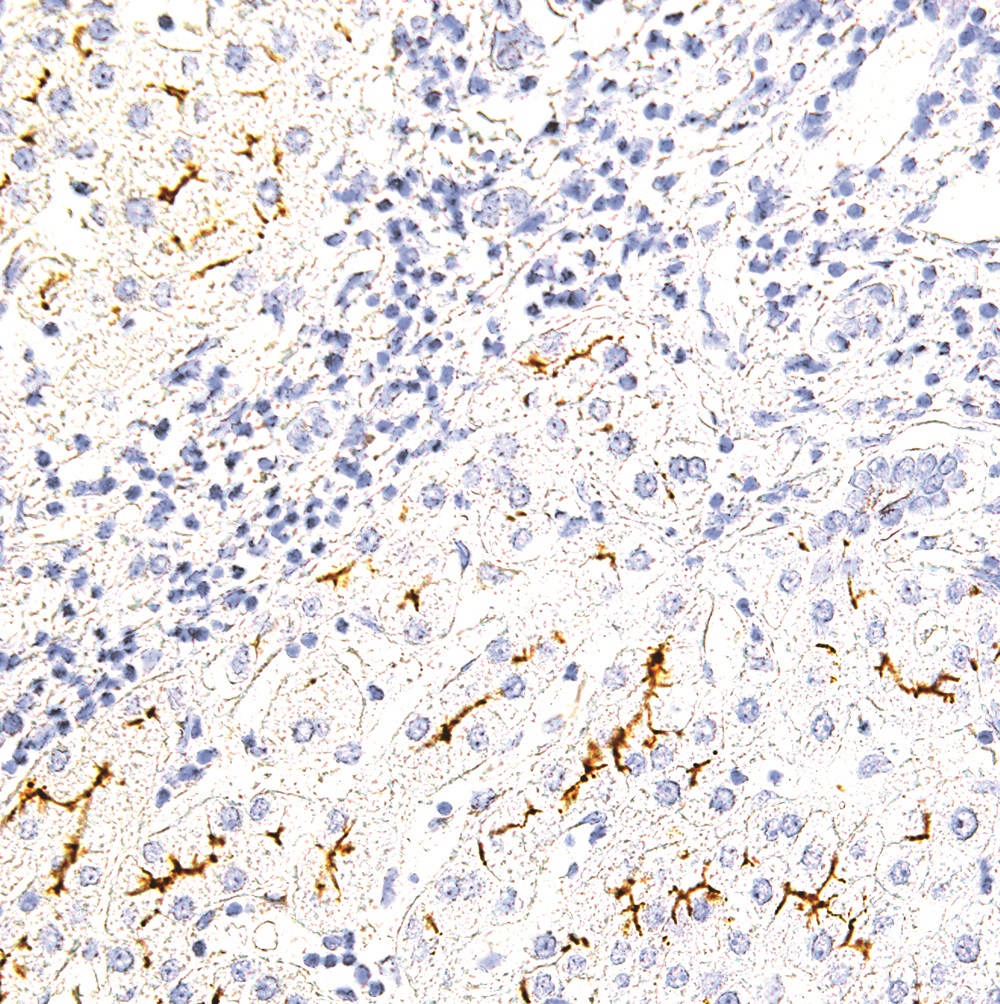

Multidrug Resistance 3 (MDR3), also known as ATP Binding Cassette Subfamily B Member 4 (ABCB4), is a membrane-associated protein belonging to the superfamily of ATP-binding cassette transporters. MDR3 is an energy-dependent phospholipid efflux translocator that mediates the translocation of phosphatidylcholine across the canalicular membrane of the hepatocyte, and also acts as a positive regulator of biliary lipid secretion. Defects in MDR3 are associated with progressive familial intrahepatic cholestasis type 3 and gallbladder disease type 1. Co-overexpression of MDR3 and MRP1 has been documented as correlating with blastemal subtype and high-risk prognosis of Wilms' tumour patients.
1 ml
| Clone | IHC621 |
| Isotype | IgG1, kappa |
| Application | IHC |
La documentazione sarà disponibile a breve, nel frattempo potete contattarci via mail a specialist@histoline.com